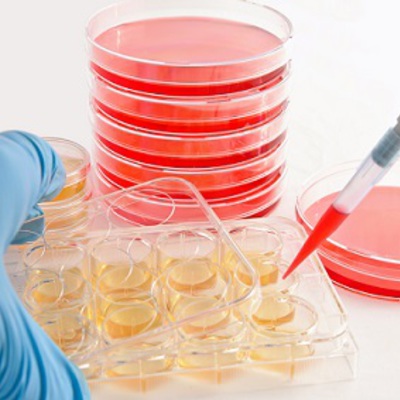

Стволовые клетки (англ. stem cell) – полипотентные клетки организма. Термин был введен в научный оборот в 1908 г. выдающимся российским учёным, членом-корреспондент РАН, А.А. Максимовым (1874–1928).
Гистолог и эмбриолог, профессор Военно-медицинской академии в Санкт-Петербурге, профессор Чикагского университета А.А. Максимов специализировался на исследовании развития клеток крови.
В результате ученый обнаружил, что в так называемом красном костном мозге живут специальные клетки, единственное предназначение которых – делиться.
После каждого деления получается две клетки, одна из них становится кровяной, а другая подрастает и снова делится.
На схематическом изображении делящиеся клетки как бы образуют «ствол», от которого в каждом цикле вбок отходят «веточки» – клетки, приобретающие специальные функции.
Поэтому А.А. Максимов назвал клетку – прародительницу всех клеток крови стволовой.
Последующие исследования привели к созданию стройной научной теории. В 60-е годы прошлого века советский гистолог, гематолог, член корреспондент Академии наук СССР, Александр Яковлевич Фриденштейн (1924–1997) обнаружил, что в костном мозге среди обычных кроветворных стволовых клеток есть небольшое количество клеток еще более пластичных.
В опытах исследователя они превращались в хрящевую, костную, жировую ткань и могли дать начало любому из примерно 300 типов клеток, имеющихся в нашем организме
Было доказано, что стволовые клетки обновляют и замещают клетки, утраченные в результате каких-либо повреждений во всех органах и тканях. Они призваны восстанавливать организм человека с момента его рождения.
В конце прошлого века учеными было доказано, что только стволовые и половые клетки способны делиться бесконечно, копируя наш генетический материал для воспроизводства и выполняя функцию регенерации. Все остальные клетки человека, как мы уже отмечали, имеют предел деления.
Один из первооткрывателей структуры ДНК Джеймс Уотсон, комментируя открытие стволовых клеток, отметил, что устройство стволовой клетки уникально, поскольку под влиянием внешних факторов она может превратиться либо в зародыш, либо в линию специализированных соматических клеток.
Стволовые клетки обладают тремя главными признаками, которые отличают их от других клеток организма:
Стволовые клетки сильно различаются по своей способности давать разные типы клеток-потомков.
Одни способны воспроизвести целый организм — тотипотентные клетки. Другие могут дифференцироваться только в клетки одного типа — унипотентные.
Со стволовыми клетками связана одна из теорий старения организма. Как показывают научные исследования, с возрастом количество стволовых клеток в организме катастрофически снижается.
Известно, что число стволовых клеток крови при рождении человека достигает примерно 20 тысяч, а в зрелом возрасте в активном состоянии их остается около 1300.
Если рассматривать соотношение стволовых клеток к обычным клеткам организма, то получим следующую динамику их возрастного сокращения:
Истощение запаса стволовых клеток лишает организм возможностей самовосстановления, и как следствие начинают доминировать процессы старения организма, появляются специфические заболевания.
Интересное исследование о влияние стволовых клеток на процесс старения провели голландские ученые. В 2005 г. в возрасте 115 лет скончалась одна из старейших женщин планеты голландка Хендрике ван Андель-Шиппер (1890-2005).
Женщина никогда не жаловалась на здоровье и до конца дней своих сохраняла ясность ума. Свое тело она завещала науке.
Авторы исследования изучили состояние ее стволовых клеток, от которых зависит продолжительность жизни.
К удивлению ученых, две трети лейкоцитов Хендрике производились всего двумя стволовыми кроветворными клетками, а остальные стволовые клетки к тому времени уже погибли.
Также анализ выявил, что теломеры в клетках крови оказались очень короткими. В связи с этим исследователи предположили, что большинство стволовых клеток крови умерли от изнашивания, достигнув предела клеточного деления.
Несмотря на то, что в клетках крови долгожительницы были найдены многочисленные мутации, все они оказались не опасными для здоровья.
Из чего ученые сделали вывод, что женщина умерла по причине того, что произошло истощение популяции стволовых кроветворных клеток.
На базе достижений исследования и применения стволовых клеток в середине прошлого столетия швейцарский врач Поль Ниханс (1882–1971) разработал метод омоложения, известный как метод «клеточной терапии».
Суть метода заключается в том, что повышение количества стволовых клеток в организме приводит к интенсивному восстановлению повреждённых тканей и больных органов за счёт образования молодых, здоровых клеток на месте утраченных.
Для омоложения используются тканевые экстракты, стволовые клетки, в том числе эмбриональные. Указанную процедуру за несколько десятилетий прошли десятки тысяч людей, включая достаточно известных политиков, бизнесменов, писателей и др., в том числе:
Сам талантливый швейцарский врач и ученый Поль Ниханс умер в 1971 г., прожив 89 лет.
В настоящее время эта теория и методика получили бурное развитие. Стволовые клетки используются не только для омоложения, но и при лечении различных болезней, репродукции отдельных органов организма с целью их последующей трансплантации.
Клеточная терапия находит применение в кардиологии. Ведутся работы по созданию методов лечения сахарного диабета, болезни Паркинсона, онкологических заболеваний и многих других недугов.
В 2006 г. доктор Саймон Хоерстрап и его немецкие коллеги из Университета Цюриха впервые вырастили человеческие сердечные клапаны, воспользовавшись стволовыми клетками, взятыми из околоплодной жидкости.
Достижение ученых – важный шаг на пути к главной цели – выращиванию полноценного сердца из стволовых клеток.
Директор Института стволовой клетки Университета Миннесоты в Миннеаполисе Катрин Верфэйл в 2006 г. продемонстрировала возможность получения из стволовых клеток взрослого организма клеток гладкой мускулатуры.
Клетки были выделены из костного мозга взрослых особей мышей, крыс, свиней и человека. Образование клеток гладкой мускулатуры из многофункциональных клеток похоже на обычное развитие мышечных клеток, причем новые клетки обладают всеми функциональными особенностями нормальных клеток гладкой мускулатуры.
Осенью 2006 г. британские ученые из Университета Ньюкасла объявили о том, что первыми в мире вырастили в лабораторных условиях искусственную ткань печени из стволовых клеток, взятых из пуповинной крови.
Японские ученые вырастили из стволовых клеток роговицу глаза. Таким же образом был получен тонкий защитный слой (конъюнктива), покрывающий роговицу снаружи. Ученые подчеркивают, что впервые полноценная ткань человеческого организма была выращена из единственной клетки.
Кроме того, ученым удалось вырастить в лабораторных условиях из стволовых клеток человека мочевой пузырь и кровеносные сосуды.
Следующий шаг – создание из стволовых клеток «собственных» органов для конкретного пациента, способных устранить потребность в донорских органах или искусственных механизмах.
Их преимущество перед донорскими органами в том, что их можно вырастить из клеток самого пациента, и они не будут вызывать отторжения. Кроме того, пересадка органов, полученных новым способом, исключает риск переноса инфекций.
Потребности медицины в трансплантационном материале практически неограниченны. На сегодняшний день только 10–20% людей восстанавливают здоровье благодаря удачной пересадке органа, остальные пациенты погибают без лечения во время ожидания операции.
Стволовые клетки в каком-то смысле действительно могут стать источниками «запчастей» для нашего организма.
В 2012 г. ученым из американского Института сердца Университета Сан-Диего удалось омолодить старые клетки сердца с помощью модифицированных стволовых клеток.
В ходе эксперимента, впервые в истории медицинской науки удалось обновить старые, поврежденные сердечной недостаточностью клетки сердца.
Это открывает совершенно новые возможности по борьбе с сердечно-сосудистыми заболеваниями, которые лидируют в списке наиболее распространенных причин смерти людей.
Ученые создали модифицированные стволовые клетки с повышенной активностью фермента теломеразы, который удлиняет длину теломер.
Исследователи модифицировали стволовые клетки человека с помощью фермента киназы PIM-1 и поместили их к клеткам сердца, взятым у пожилых людей.
В результате обнаружилось, что процесс старения клеток буквально повернулся вспять, наблюдался активный процесс восстановления мышцы миокарда.
В ходе экспериментов на мышах модифицированные киназой PIM-1 стволовые клетки всего за четыре недели удлинили теломеры сердечных клеток и вызвали рост новых тканей сердца.
Новая технология восстановления сердца потенциально может во многих случаях заменить трансплантацию этого органа и вернуть здоровье людям, перенесшим тяжелые инфаркты и другие распространенные сердечные заболевания.
В настоящее время ученые занимаются совершенствованием методики удлинения теломер и проверкой ее безопасности.
По мнению специалистов, в ближайшие 10–15 лет следует ожидать прорыва, который поставит выращивание тканей и органов на поток.
В результате сложных манипуляций со стволовыми клетками мыши группе японских исследователей из Токийского университета наук (Tokyo University of Science) под руководством профессора Такаси Цудзи (Takashi Tsuji) удалось вырастить новый коренной зуб.
Соединив вместе капли специального геля двух разных видов стволовых клеток и подвергнув их дополнительной обработке, ученые сначала получили зародыш будущего зуба.
Далее пятидневный зародыш зуба был помещён в десну. Для отслеживания за растущей тканью зуба в клетки был добавлен ген зеленого флуоресцентного белка.
Флуоресцентный белок позволял видеть исследователям, куда именно мигрировали клетки искусственного зуба, и убедиться в том, что наряду с зубами у грызунов не появилось каких-нибудь новообразований.
Новый зуб прорезался через 36 суток и полностью вырос через 49 дней. Зуб прочно укрепился в костной ткани челюсти, сохранив естественный уровень чувствительности.
Внутри зуба образовалась пульпа, дентин, проросли нервные волокна и кровеносные сосуды. У нового зуба оказалась крепкие корни и столь же крепкая эмаль, как у остальных зубов.
На рентгеновских снимках и фотографиях, сделанных учеными, выращенный новый биоинженерный зуб ничем не отличается от обычных, а по прочности не уступает собственным зубам мыши.
Для подтверждения практических результатов генетиков эксперимент был повторен несколько раз.
Исследователи полагают, что их работа обеспечивает если не получение новых зубов в стоматологических клиниках, то как минимум создают лабораторную модель для дальнейших поисков методов выращивания новых биоинженерный зубов.
По мнению ученых подобная технология может быть перенесена на человека примерно через 10-15 лет.
Уникальные результаты исследований японских ученых по выращиванию зубов были опубликованы в 2016 г. в научном журнале Национальной академии наук США «Proceedings of the National Academy of Sciences».
Первые успехи клеточной терапии приводят к пониманию того, что каждый человек должен иметь запас собственных стволовых клеток для лечения различных болезней.
Самым доступным источником стволовых клеток взрослого человека является его костный мозг, так как концентрация стволовых клеток в нем максимальная.
В костном мозге выделяется сразу два вида стволовых клеток, из одних формируются абсолютно все клетки крови, а вторые восстанавливают практически все органы и ткани.
С целью использовать стволовые клетки для лечения различных заболеваний в течении жизни человека в США и других странах уже много лет практикуется взятие крови из пуповины новорожденного малыша с последующим ее замораживанием.
В дальнейшем, если у этого ребенка или уже взрослого человека возникнут проблемы со здоровьем, его замороженные стволовые клетки можно разморозить, размножить и направить их в организм для восстановления определенного типа клеток.
В настоящее время такие возможности появляются и у российских граждан. Аналогичную услугу стали оказывать в некоторых отечественных роддомах.
Долгое время единственным материалом для клонирования стволовых клеток были эмбрионы и пуповинная кровь новорожденных.
Однако в 2014 г. группе американских ученых, возглавляемых доктором Робертом Ланзой из биотехнологической компании «Advanced Cell Technology» удалость получить стволовые клетки из тканей организма двух взрослых мужчин соответственно 35 и 75 лет.
Процесс, называемый переносом ядра, предполагает взятие ДНК от донора и введение в яйцеклетку, лишенную собственной ДНК. В результате они образуют единое целое и начинают делиться.
Полученные в результате этого процесса стволовые клетки ученые извлекают и продолжают выращивать их в лаборатории.
Благодаря этому открытию ученые смогут генерировать здоровые клетки в организме при лечении различных заболеваний.
В 1999 г. известный авторитетный научный журнал «Science» признал открытие стволовых клеток третьим по значимости событием в биологии после расшифровки двойной спирали ДНК и программы «Геном человека».
Андрианов Владимир
Профессор МГУ, д.э.н., бывший Помощник Председателя Правительства РФ
